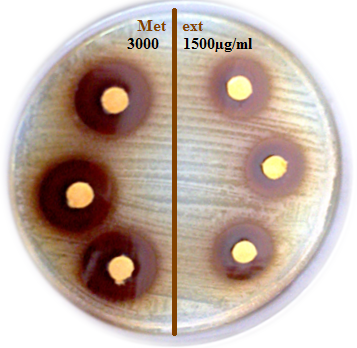
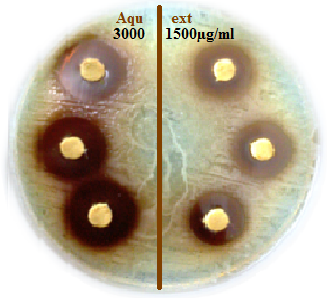

1Laboratory of Applied Biochemistry, Department of Biology, Faculty of Sciences, University of Ferhat Abbas setif-1, 19000, Algeria, 2Laboratory of Electrochemistry, Molecular Engineering and Redox Catalysis, Department of Process Engineering, Faculty of technology, University of Ferhat Abbas setif, 19000, Algeria.3Laboratory of Microbiology, University Hospital of Setif, 19000, Algeria.
Email: houchi.selma@gmail.com
Received: 04 Aug 2014 Revised and Accepted: 05 Sep 2014
ABSTRACT
Objective: to evaluate Metallo-betalactamase (MBL) inhibitory effect and antimicrobial activity against acinetobacter baumannii of methanolic and aqueous extracts of Terminaliachebuladried fruits.
Methods: effect of EDTA (Ethylenediaminetetraacetic acid), methanolic and aqueous extracts of dried fruits of T. chebula on Metallo-betalactamase activity was studied in vitroby using cephaloridin asasubstrate. The degree of inhibition was determined byIC50and the antimicrobial activities of both extracts against Acinetobacter baumannii were qualitatively and quantitatively assessed by the presence or absence of inhibition zones, MIC and MBC values.
Results: EDTA, methanolic and aqueous extracts inhibit metallo-betalactamases activity withIC50(3.98 mM, 18.45 and 19.68µg/ml), respectively. Polyphenols in aqueousand methanolic extracts are 513.094±3.061 and 496±2.856 µg GAE/mg, respectively.
Conclusion: These results indicate that both extracts of T. chebula are rich in polyphenols and have a strong inhibitory effect on metallo-betalactamases in a competitive manner compared to EDTA. In addition, both extracts of T. chebula were also screened for their remarkable antibacterial and bactericidal activity against Acinetobacter baumannii confirmed by low minimum inhibitory and bactericidal concentration (MIC and MBC).
Keywords: Metallo-betalactamases, Acinetobacter baumannii, Terminaliachebula, Cephaloridin, EDTA.
INTRODUCTION
Bacteria have developed several resistance mechanisms against beta-lactam antibiotics. Among them, generation of beta-lactamases, which hydrolyzethe amide bond in beta-lactam rings to inactivate beta-lactam antibiotics. Beta-Lactamases can be grouped into four classes according to their sequence homology [1]. Class A, C, and D enzymes, generally called serine betalactamases, use a serine residue in their activesite to hydrolyze b-lactam antibiotics [2]. Class B enzymes, also called Metallo-Beta-Lactamases (MBLs), and are characterized by one or twozinc ions (Zn) that are indispensable for their activity [3]. The clinical inhibitorsfor these enzymes are not known [4]. EDTA is the only known inhibitor used forits detection [5]. The MBLs are further divided into B1, B2, and B3subclasses [6]. Both B1 and B3 subclasses have a broad-spectrum substrate profile including penicillins, cephalosphorins andcarbapenems. In contrast, the B2 subclass enzymes primarily hydrolyze carbapenems [7].
Medicinal plants have long been utilized as a source of therapeutic agent. Plants are known to produce different secondary metabolites which are naturally toxic to bacteria. Lin et al proposed the combination of antibiotics and flavonoids as a potential new strategy for development of new therapies in the future, for infections caused by extended spectrum of betalactamases (ESBLs) producing bacteria [8]. Terminaliachebula Retz indigenous to Pakistan and India, is a member of the Combretaceae family.
The dried fruit of T. chebula (Chebulae Fructus), commonly known as black myrobalan in English and Xi-Qin-Ge or Zhang-Qin-Ge in China, have traditionally been used as a popular folk medicine [9] for alternative, astringement,denrifrice, purgative, stomachic, tonic, antiseptic, cardiotonic and laxative purposes. This fruit is also useful for burns, digestive disorders,diabetes, eye diseases, weak eye sight, fever, skin diseasesand kidney dysfunction along with other herbs [10]. In efforts to find new bioactive beta-lactamases inhibitors, which can be used against the resistance strain Acinetobacter baumannii, this study investigated the aqueous and methanolic extracts of Terminalia chebula dried fruits,which were evaluated for their inhibitor effect on metallo-betalactamases and antibacterial activity against Acinetobacter baumannii producing MBLs; where the kinetics parameters were investigated.
MATERIALS AND METHODS
Plant material
The dried fruits were purchased from a local herbal market in Setif, Algeria, in February 2013 and were identified as fruit of Terminaliachebula (Family: combretaceae) by Prof. LAOUERH, Department of Ecology and Vegetal Biology, University Setif-1; then it was powdered using a coffee grinder (Moulinex, Paris, France), and utilized in our studies.

Bacterial strain
TheA. baumanniistrain was collected from a hospitalized patient at Setif University Hospital in 2013. It was identified with a series of 20 ready biochemical compounds (API-20 E gallery, Biomérieux -France-).
Chemicals
All chemicals used were purchased from Sigma Aldrich (Germany)and all solvents were distilled before use.
Preparation of extracts
Methanolic extract was prepared by maceration of30 g of dried fruit powder ofT. chebulain 80% methanolfor 48 h, with continuous stirring at room temperature; after filtration, the filtrate was concentrated under reduced pressure at 40 °C and centrifuged. Aqueous extract was prepared by decoction of 30 g of dried fruit powder of T. chebulain 300 ml of distilled water at 100°C for 20 min; the decoction obtained was filtered with a Whatman paper (pore size 3 μm) then centrifuged.
Estimation of total phenolic content
Total phenolic content of aqueous and methanolicextracts was determined by the Folin-Ciocalteumethod [11].
Preparation of β-lactamases
A. baumanniistrain was grown in 1.5 mlof brain heart infusion (BHI) at 37°C with 250µg of imipenem under vigorous agitation for 24h. The cells were concentrated by centrifugation at 18000 × g for 30 min, and crude enzymatic preparations were made by sonicating (vibracell-USA) for 12 seconds (two cycles) with 12 seconds cooling in between sonications; this was repeated seven times. The lysates were centrifuged at 4°C, 20 000 x g for 30 min. Nucleic acids were precipitated by the addition of 2% streptomycin sulfate and centrifuged at 18000 × g for 30 min. The supernatant was dialyzed overnight and concentrated with polyethylene glycol (PEG) against phosphate buffer (pH 7, 0.5M) and used for further analysis.
Characterization of betalactamases
Acinetobacterbaumannii was confirmed to be MBLs producing isolates by the imipinem-EDTA combined disc test (CDT), substrate profile, and their sensitivity to EDTA and clavulanic acid.
Imipinem-EDTA combined disc test (CDT)
The MBL phenotypic detection method employed was the imipinem-EDTA combined disc test (CDT). TheAcinetobacterbaumanniistrain was adjusted to the McFarland 0.5 standard and were used to inoculate Mueller-Hinton agar plate, Two 10 µg imipenem discs were placed on the surface of the agar plate and EDTA (0.5M, pH8) solution was added to one of them to obtain a concentration of 1900 µg. The inhibition zones of imipenem and imipenem-EDTA discs were compared after 16-18 h of incubation at 35°C.
Determination of β-lactamases activity
All reactions were performed at 30°C in 0.65 ml of assay buffer (50 mM HEPES; pH 7.2; 50 µM ZnSO4; 150 mMNaCl and 0.005 mg BSA/ml) and 10 µl semi-purified extract of metallo-betalactamases.
Different classes of betalactams antibiotics (penicillin G [ε235 nm= 560M-1 cm-1], cephaloridin [ε260 nm = 1000 M-1. cm-1], imipenem [ε299 nm = 9000 M-1. cm-1] and aztreonam [ε320 nm = 700 M-1. cm-1]) were used as substrate to determine the kinetic parameters Km and Vmax. The assays were performed using a UV-1800 spectrophotometer (shimadzu, JAPAN) by observing changes in absorption resulting from the opening of the β-lactam ring at specific wavelengths for each antibiotic evaluated. The results are presented as the average±standard deviation based on four independent measurements. The protein concentration of semi-purified extract were determined using the Bradford assay [12]; the CoomassiePlus protein assay reagent and bovine serum albumin as a standard. Kinetic parameters were derived from the initial velocity using SIGMAPLOT 12.0.
Assay of Metallo-betalactamases inhibitory activity
To examine the inhibition effect of EDTA,clavulanic acid, aqueous and methanolic extracts, an enzyme assay was performed by determining the IC50, which is defined as the concentration of inhibitor necessary to inhibit 50% MBLs activity. The assay was performed under previously described conditions after incubating the reaction mixture for 10 min with varied concentrations of EDTA (1µM to 5 mM),clavulanic acid (1µM to 7 mM), aqueous and methanolic extracts (1µg/ml to 1mg/ml); respectively, before initiating the reaction with cephaloridin. Percentage of Inhibition of beta-lactamase was calculated as follows:
Inhibition % = 100 x (AC – Ae)/AC
Where, AC: metallo-betalactamase activity without inhibitors, and Ae: metallo-betalactamase activity in the presence of plant extracts or inhibitors.
Antibacterial activity
The antibacterial effect of methanolic and aqueous extracts of Terminaliachebula dried fruits was tested against Acinetobacter baumannii using disc diffusion assay described by Genç et al [13]. Briefly, 20 ml of Muller-Hinton (MH) agar were poured in sterile Petri plates and allowed to solidify. Then, 100 µl of overnight test A. baumanniicultures were spread on the surface of the dried MH agar. Sterile antibiotic discs (6 mm diameter) were placed on the surface of the inoculated plate and filled with 1500 and 3000 µg/ml of the extracts. Gentamycin (10 mg/disc) was used as a reference antibiotic control, whereas, sterile distilled water was the negative control. After incubation at 37°C for 24 hours the growth of inhibition zones formed around the disc were measured with a transparent ruler in millimeterand documented. The solvent used was tested and did not show any inhibition of bacterial growth. The results are averages of triplicate tests±standard deviation.
Determination of MIC and MBC
Minimum inhibitory concentration (MIC) was done by the method described by Verporte et al. [14]. Briefly, the extracts were incorporated into Mueller-Hinton broth at concentration ranging from 0.01-1mg/ml. A control tube containing the growth medium and A. baumannii was set-up. The mixtures were incubated at appropriate temperature of 37°C for 24h. The minimum inhibitory concentration (MIC) of the extracts was regarded as the lowest concentration of the extract that did not permit turbidity or growth of A. baumannii.
Minimum bactericidal concentration (MBC) value was determined by sub culturing the test dilution [which showed no visible turbidity] on to freshly prepared nutrient agar media. The plates were incubated further for 24 h at 37°C. The highest dilution that yielded no single bacterial colony on the nutrient agar plates was taken as MBC.
RESULTS
Total phenolic contents
The determination of total phenolic contents of aqueous and methanolic extracts of Terminalia chebula dried fruits was conducted using Folin-Ciocalteu, it was expressed as µg gallic acid equivalent per mg dried extract (µg GAE/ mg E). Polyphenols in aqueous and methanolic extracts are 513.094±3.061 and 496±2.856 µg GAE/mg dried extract, respectively. These values showed that the both extracts are rich in phenolic compounds.
Confirmatory test
In this study, the imipinem-EDTA combined disc test (CDT) was used as a phenotypic confirmatory method for metallo-betalactamases production. An increase in the inhibition zone of EDTA+IMP in comparison with IMP was interpreted as a positive result for metallo-betalactamases production. Our study showed that a disk with imipenem plus 1900 µg of EDTA increase the mean inhibition zone diameter by 17 mm (8 mm with IMP; 25 mm with EDTA+IMP), However, this test was positive for A. baumanniiimipenem resistant isolate, indicating metallo-betalactamasesproduction (Figure 1).
Fig. 1: It Shows MBL combined disc test positive of Acinetobacterbaumannii
Βeta-lactamases activity
The kinetic parameters of the semi-purified metallo-betalactamase, including Km and Vm, were determined using different β-lactam class. Under the adopted experimental conditions, this enzyme is able to hydrolyseall tested b-lactam antibioticsincluding benzylpenicillin, cephaloridin and imipenemexcept aztreonam (monobactam). From these results, the semi-purified metallo-betalactamase is cephalosporinase showing the highest activity with cephaloridine as substrate (Vmax / Km = 8.80±0.014). The enzyme showed low activity and less affinity for imipenem than other substrate (Table 1).
Sensitivity to EDTA and clavulanic acid
Examination of the semi-purified metallo-betalactamase from A. baumannii in the presence of cephaloridin with and without EDTA and clavulanic acid illustrated that themetallo-B-lactamase activity was inhibited in thepresence of EDTA with IC50=3.98 mM in a competitive manner. The clavulanic acid had no effect on thesemi-purified metallo-betalactamase.
The inhibitory effect of methanolic and aqueous extracts
The objective of this part of study was to evaluate the inhibitory effect ofmethanolic and aqueous extracts on the metallo-betalactamases of Acinetobacterbaumannii. The enzyme activity was tested in the presence of increasing concentrations of both extracts of Terminaliachebula dried fruits. The IC50 of EDTA against this MBLs was 3.98 mM. Therefore, MBLs were more susceptible to methanolic and aqueous extracts of T. chebula dried fruits with IC50 values 18.45 and 19.68µg/ml, respectively, than EDTA.
Table 1: Kinetics parameters of metallo-betalactamases with betalactams antibiotics
| betalactams class | substrate | nm | Km (µM) | 1Specific activity | 2Efficiency of hydrolysis |
| penem | Penicillin G | 235 | 14.92±0.00888 | 80.64±1.147 | 5.40±0.036 |
| cephem | cephaloridin | 260 | 15.15±0.009 | 133.33±2.036 | 8.80±0.014 |
| carbapenem | imipenem | 299 | 47.62±0.012 | 52.57±0.973 | 1.10±0.002 |
| monobactam | aztreonam | 320 | ∞ | 0 | 0 |
1 µmol of substrate hydrolysed per mn and per mg of protein (µmol. min-1. mg-1), 2 µmol. min-1. mg-1/Km, The results are mean±SD (n=4)
Table 2: Antibacterial activity of methanol and aqueous extracts of Terminaliachebuladried fruits
| organism | Zone of inhibition in (mm) at 1500µg/disc | Zone of inhibition in (mm) at 3000µg/disc | ||
| A. baumannii | Methanolic extract | Aqueous extract | Methanolic extract | Aqueous extract |
| 17.5±1 | 18±0.5 | 22.5±0.5 | 24±0.25 | |
The results are mean±SD (n=3)
Table 3: Antibacterial activity of methanol and aqueous extracts of Terminaliachebuladried fruits
| organism | MIC (µg/ml) | MBC (µg/ml) | MBC/MIC |
| A. baumannii | Methanolic extract | Aqueous extract | Methanolic extract |
| 31.25±0.000 | 31.25±0.000 | 62.5±0.000 |
The results are mean±SD (n=3), MIC: Minimum inhibitory concentration , MBC: Minimum bactericidal concentration
Aqueous and methanolic extracts at different concentrations showed that they inhibit the enzyme activity in a dose dependent manner. The inhibition percentage was determined for each concentration, in the range of 10 to 40 µg / ml, the inhibition increased from 23.52±0.0123% to 90.70±0.033% of the methanolic extract and 21.72±0.0265% to 87.96±0.098% of the aqueous extract.
Antibacterial activity
The antibacterial activity of methanol and aqueous extracts of dried fruits of T. chebula against A. baumannii were measured by measuring the zone of inhibition in disc diffusion method (Figure 2). Test sample per disc was about 1500 and 3000µg/disc. The zone of inhibition of methanolic and aqueous extracts is shown in Table 2. Negative control and Gentamycin did not show any inhibitory effect against A. baumannii.

Fig. 2: ItShows the Antibacterial activity of methanolique and aqueous extracts of Terminaliachebuladried fruits at 1500 and 3000 µg/ disc against Acinetobacterbaumannii.
Minimum Inhibitory Concentration (MIC) and Minimum Bactericidal (MBC)
MIC and MBC values obtained from the extracts of T. chebula, revealed that aqueous and methanolic extracts had the same MIC and MBC values: 31.25±0.000 and 62.5±0.000, respectively; MBC is twofold higher than MIC and the MIC/MBC ratio is 2 (Table 3).
DISCUSSION
Betalactamases can be divided into serine-ß-lactamases and metallo-ß-lactamases, which employ a serine and one or two zinc ions in the active site, respectively [15]. Except monobactams, the MBLs can degrade almost all classes of ß-lactamsincluding carbapenems, which are stable against theserine-ß-lactamases. The currently clinical used beta-lactamase inhibitors such as clavulanic acid, sulbactam,and tazobactam can poorly inhibit MBLs [16]. In this study, the positive result of CDT, inhibition by EDTA, insensitivity to clavulanic acid and the ability to hydrolyze all classes of betalactams except aztreonam establishes the enzyme as a metallo-beta-lactamase.
EDTA is a metallo-chelator known to potentiate the activities of some lactam antibiotics against MBL-producing microorganisms because the zinc-containing active site of MBL is inactivated by EDTA[17],[18]. In this study, we found that EDTA inhibit hydrolysis of cephaloridin by MBLs but with high concentration, indicating a stronger activity of MBLs in the extract of A. baumannii. Despite the toxicity of chemicals compounds as EDTA, which hinders its clinical use [19], research of natural MBLs inhibitors and alternative antibacterial drugs is an urgent need. The use of plant derived natural compounds used as alternative sources of medicine continues to play major roles in the general wellness of people all over the world. The curative properties of medicinal plants are due to the presence of various complex chemical substances of different composition which occur as secondary metabolites such as phenolic coumpounds. Methanolic and aqueous extracts of T. chebula have been reported to exhibit a variety of biologic effects [20], and antimicrobial activity [21]. In the present study, we compared the inhibition effects of EDTA with methanolic and aqueous extracts of T. chebula dried fruits on MBLs of the extract of A. baumannii. Therefore, MBLs were more susceptible to methanolic and aqueous extracts of T. chebula dried fruits than EDTA. We were still curious if there is an effect on the Acinetobacterbaumannii strain as the inhibitory effect of the extracts of Terminaliachebula on the semi-purified extract of metallo beta-lactamase of the same strain, for this reason, the extracts of Terminaliachebula dried fruits were alsoscreened for their antimicrobial activity against Acinetobacterbaumannii strain; The result showed that the methanolic and aqueous extracts of T. chebula dried fruits which have a strong MBLs inhibitory effect are potentially a rich source of antimicrobial agents (polyphenols) that confer a good antibacterial activity against A. baumannii with the same MIC and MBC; The MIC/MBC ratio indicated that extracts are bacteriostatic at lower concentration, while at higher concentration, are bactericidal. These effects could probably be due to phenolic compounds such tannin and flavonoids present in theT. chebuladried fruitsextracts, which needs to be confirmed. Tannins act similar toEDTAso iscapable to inhibit MBL which isan enzymethatrequires Zn2+ foritsmode of action and is known also to show the antibacterial activity by precipitation the microbial proteins. Flavonoids are produced by the plants for the defense against the infection. So, the use of the methanolic and aqueous extract of this plant as an agent to decrease the resistance of A. baumannii to betalactams antibiotics needs further extensive research for their better economic and therapeutic utilization. The findings from this work may add to the overall value of the medicinal potential methanolic and aqueous extracts of T. chebula. Further phytochemical studies are required to determine the purified fractions/bioactive compounds responsible for the MBLs inhibitory and antibacterial activities of these species.
CONCLUSION
The results obtained in the present study can be concluded that Acinetobacterbaumanniiis resistance to betalactams antibiotics by production of Metallo-betalactamases. Aqueous and methabolic extracts of Terminaliachebula are rich in phenolic compounds; possess in vitro significant inhibitory effect on MBLs activityand have also a good antibacterial activity against A. baumannii confirmed by low minimum inhibitory and bactericidal concentration (MIC and MBC). T. chebula dried fruit can therefore be used as a natural antibacterial agent for the treatment of several infectious diseases caused byAcinetobacterbaumannii.
CONFLICT OF INTERESTS
Declared None
ACKNOWLEDGEMENTS
This study was supported by grants from the Algerian Ministry of Higher Education and scientific research. Authors express our gratitude to this Ministry.
REFERENCES